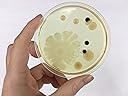
Thumbnail 8

Buy anything from 5,000+ international stores. One checkout price. No surprise fees. Join 2M+ shoppers on Desertcart.
Desertcart purchases this item on your behalf and handles shipping, customs, and support to Indonesia.
Great for a classroom microbiology lesson. Kit contains enough supplies for ten students and is packaged in individual kits so each student has what he or she needs to perform the experiment. Swab different surfaces and watch what grows! ONE OF THE BEST SELLING BACTERIA GROWING SCIENCE FAIR KITS. Kit Contains: 20 Pre-Poured 15x100mm agar plates20 Cotton Swabs10 Pair Nitrile GlovesStep-by-step instructions ★ FREE eBook filled with experiments to try! When you receive our kit, don't forget to request your free Experiment Project Guide eBook!★ EXPLORE & LEARN! With our pre-poured agar plate bacteria growing set, you don’t have to pour your own plates, which is time consuming and could be dangerous. Learn about microbiology and great for science fair projects. Each plate is coated with a thick nutrient rich agar, which is the same thing microbiologists use in the lab to grow and study bacteria, molds, and other fungi.
Trustpilot
2 weeks ago
1 month ago